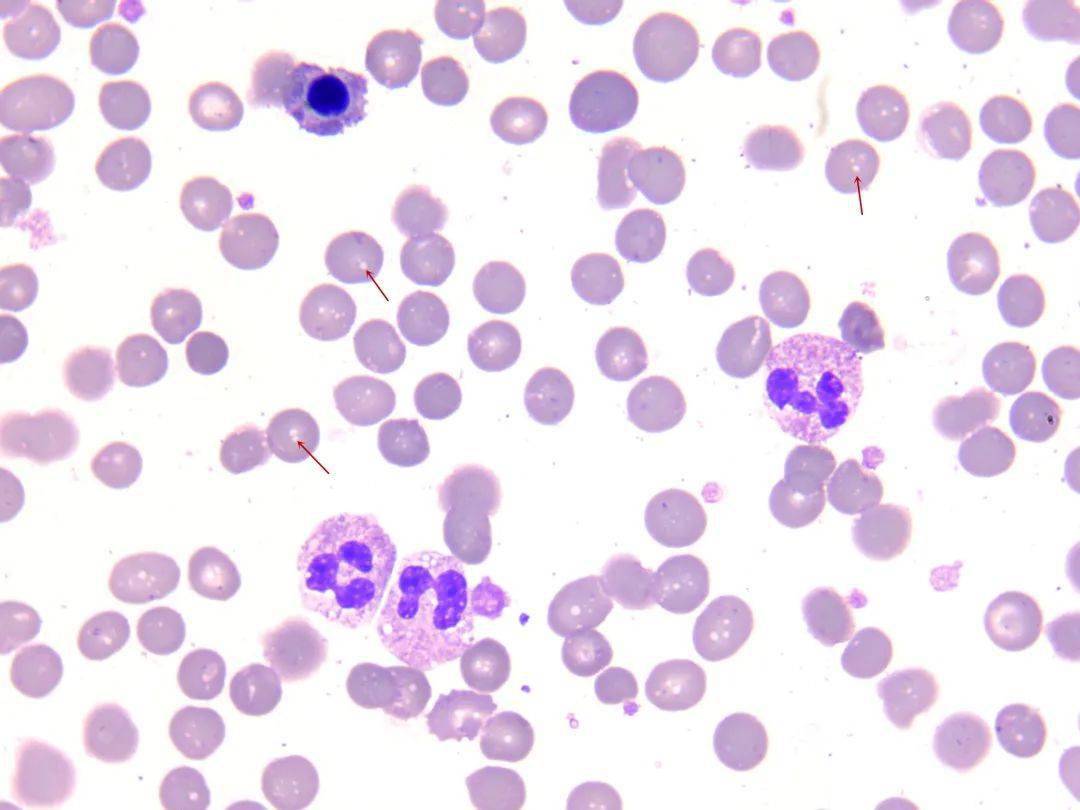
红细胞间隙一层粉尘感,如箭头所示 低倍镜(10×10)考虑到 mchc>380g/l

MCHC

根据mcv,mch,mchc确定贫血类型
图片尺寸500x254
案例我赌你没见过20000多的mchc
图片尺寸3106x4096
小儿贫血概述ppt
图片尺寸1080x810
四,mcv,mch,mchc
图片尺寸631x277
成分:本品由葡萄糖酸钙,磷酸氢钙(mchc),椰子油,欧米伽-3脂肪酸
图片尺寸800x800
红细胞平均血红蛋白浓度mchc小指标大作用
图片尺寸818x811
患者李某edta管血常规的q-flag(经水浴30分钟后)各项目包括mchc均正常
图片尺寸554x320
mchc908qt4cdwe【ic mcu 8bit 4kb flash 8so】
图片尺寸640x640
及报警均显示异常:可见红细胞与血红蛋白比例严重失衡,mchc异常增高
图片尺寸660x880
红细胞间隙一层粉尘感,如箭头所示 低倍镜(10×10)考虑到 mchc>380g/l
图片尺寸1080x810
认识血常规解读红细胞的秘密
图片尺寸1053x704
各位医生要注意血常规检查别忽略了mchc
图片尺寸601x563
医药卫生 血液检查ppt 血液检查 红细胞平均值(mcv,mch,mchc)的检测
图片尺寸1080x810
因为感觉如果只看mchc的话就应该有大细胞高色素性贫血这个分类了.
图片尺寸1013x366
金湾金器气缸气爪mchc一20-2 库存商品 看成色应该未使
图片尺寸720x1041
平均红细胞体积(mcv),平均血红蛋白量(mch),平均血红蛋白浓度(mchc)
图片尺寸600x763
红细胞平均血红蛋白浓度mchc小指标大作用
图片尺寸1080x489
mchc908jk1ecpe『ic mcu 8bit 1.5kb flash 20dip』 现货
图片尺寸640x640
计数 血红蛋白测定(hb) 血细胞比容(hct) 红细胞平均值(mcv,mch,mchc)
图片尺寸1080x810
如下面这份血常规报告,mcv,mch,mchc数值均显著减少,最后诊断为小细胞
图片尺寸480x378